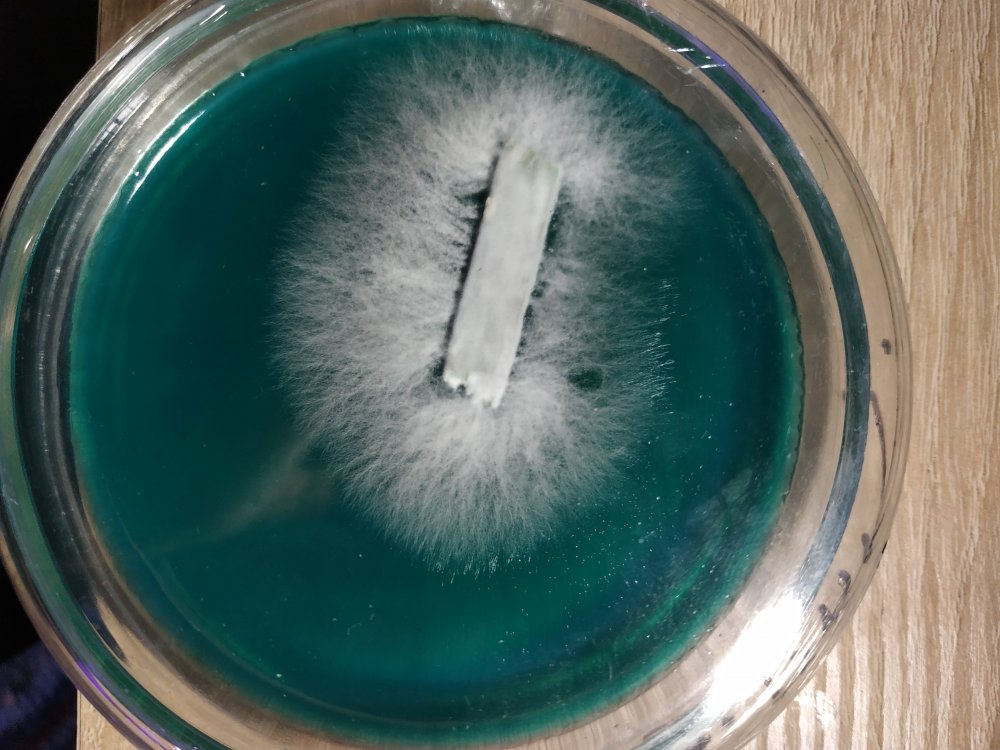

-
Публикаций
35 -
Зарегистрирован
-
Посещение
-
Победитель дней
1
Весь контент Федот
-
-
Сложно с ним, почти вся генетика долхлая. И не плодоносит. Повезло с одним только, с него получил свежую генетику, и это уже его мультиспоровые дети. Оно того стоило, считаю))
-
-
Дышат, и ой как хорошо. Анаэробы только дрожжи. По поводу колонии, не думаю что так, всегда фермы работают с моноштамом. Конечно если речь идёт про покупной миц. Если это самопал. Из леса или из спор( вдруг) то конечно может быть и такое
-
Они чудесны! Очень красивый штамм, у k-17 по внешнему виду выигрывают очень сильно. Эта " толстая нога" точно не задохнулись. При высоких показателях со2 , ноги наоборот вытягивает, сушит примордии. В сухом остатке это или деградация, что мало вероятно, с первого засева мутации почти не встречал. Обычно к такому склоненно, много раз пересеянное зерно. Или состав вторичного субстрата.
-
5.02 Инокуляция. Автоклав остыл, остыло и его содержимое, а значит время пришло... Тут ничего нового и интересного, процессы давно изученны и у многих уже давно въелись в мышечную память. Как на больших фермах, вводят шприцами инокулят, в пакеты и банки, виращивая тонны грибов. Точно также и дома, гровер инокулирует, свои баночки с перловкой, надеясь на урожай, исчисляемый уже в граммах)))) VID_20230205_164312(0).mp4 Вношу по 5 мл инокулята на банку, равномерно распределяя его по всей поверхности субстрата. По скольку, перетряхиваний не будет. Рис, прекрасен как источник питания, его способность впитывать в себя большое количество воды тоже тяжело переоценить. Но к сожалению без тщательной промывки, как в этот раз, он слипается, и слипается так что становится практически монолитным куском еды))) VID_20230205_164847(0).mp4 По этому распределяю инокулят, при введении, без маракасов в этот раз) Готово! Но осталось самое важное. Я считаю этот последний момент, равноценно важным самому процессу инокуляции. Подписать! Подписать все! Стикеры, стикеры, стикеры на все! На наклейках указанно: культивируемый вид, дата инокуляции, номер банки инокулята. Это поможет, в последующем, легко определить культивируемый вид. Оценить активность роста мицелия. А так же, опознать виновника в случае контаминации. Так же в микологический блокнот, записан состав Пит среды, которая была использована в эту дату для корди. Туда же будет записанно время колонизации, температура колонизации, начало плодоношения, температура для плодоношения, дата харвеста,% выхода плодовых тел. Это сделано сегодняшним Федотом, для Федота в будущем Сломал я этот временной континуум, по скольку прекрасно знаю что когда, через месяц, через год, а может и через два. Когда я снова вернусь к грову корди. Эти записи послужат дном от которого можно будет оттолкнуться.
-
Вид: Cordyceps militaris Штамм: 1862 Составы сред. Жидкая среда: г/л: глюкоза – 40 г/л дрожжевой экстракт – 5 г/л KH2PO4 – 1( он же монофосфат калия) MgSO4 – 0,25( он же сульфат магния) VID_20230204_111745_919.mp4 Среда культивации: рис - 1 кг Пептон - 20 г Сухое молоко - 20 г Яичный порошок - 10 г Соевый протеин - 10 г Сухие дрожжи 10 г Гипс - 5 г KH2PO4 - 2 г MgSO4 - 2 г Вода 1100 г Цель грова, в первую очередь, это получение спорового материала этого вида грибов. Ну и естественно суп под интригующим названием : 冬虫夏草のスープ Получение спорового материала очень важно, так как мицелий корди, склонен к быстрому старению, и последующей деградации штамма. 3. 02. 23 Был приготовлен быльен по рецепту. Все сухие компоненты смешаны и разведенны водой, в указанных выше пропорциях. После чего эта смесь была разлита в полипропиленовые литровые ведра с не варенным бурым рисом. Получилось элегантное блюдо, достойное пары звёзд мишлен. Рис сварится и впитает в себя бульен, уже в автоклаве. Я сделал 7 порций по 100 г риса/ 110 бульена, в каждом ведре. И отправил их на стерелизацию в автоклав на 1.5 часа. Ради разумного использования места в автоклаве, и для того чтобы рису было не скучно одному, вместе с рисом туда отправились 4 ведра пшеницы для ши и ежовика. to be continued...
-
Впервые слышу про тыкву, оч интересно. Дай ссыль почитать. А то Гугл по запросу тыква+ мицелий выдает только рецепты пирогов))) Штамм, лучше выбирать отталкиваясь от условий которые ты сможешь обеспечить, в первую очередь. Многим больше подойдет теплолюбивый, для квартирной культивации. А если есть камера роста где ты можешь добиться оптимальной температуры, и газообмена. То бери коммерческий, не пожалеешь.
-
Хмммм... Странно, видел вёшенку дикоря, на тополях часто. И трутовики, тоже встречаются часто на нем. По идее должен рейши расти, но я не пробовал, так догадки.
-
Затрону полезную, как мне кажется, для многих тему. Длительного хранения мицелия. 1. Классическая чашка Петри имеет огромное количество плюсов, на ней хорошо видно колонии бактерий, вражеские грибы, но она не подходит для длительного хранения культуры. За щет большой площади агаровой среды, гриб достаточно быстро съедает Пит вещества и умерает от голода. В среднем мои ЧП живут 2 года. Что внушительно, но можно и дольше) В пример моя двухлетняя чашка с степной вешанкой( эринги). VID_20211214_150155.mp4 2. скошенный агар в пробирке, за щет того что гриб долго проникает вглубь агара, Пит вещества потребляются постепенно. Этот способ позволяет хранить культуру очень долго. Но у этого подхода есть и недостатки. Нужен высокий скил. Лично у меня начинается паника когда нужно засунуть пол скальпеля в узкое горлышко пробирки чтоб вырезать маленький кусочек агара. Все нутро кричит : это не чистая работа! Это одни из первых моих пробирок, культура вешенки штамма НК-35, жива до сих пор, а это 3,5 года. 3. Хранение на древесине. Подходит только для грибов, которые в природе ею и питаются. Работа с чопиками или палками- мешалками, ещё проще чем с агаром, не нужно ничего резать, взял пинцетом одну и перенес куда угодно, хоть сразу в блок, хоть на зерно. Из преимуществ это то, что на древесине жить бактериям и грибам не приспособлены к питанию целлюлозой, чертовски тяжело. В пример чашка заражённая ежовиком, жившим на палочке 3 года.
-
Ну а чего бы и нет? Стеметс также свои БАДы делает с ежовиком. Да я такие пакую, но как по мне плодовые тела поярче.
-
Чопики? Мужик плесень выращивал, вот продолжения и нет( Вообще чопики, палки мешалки, прикольная тема, хендмейд мой работает норм. Вот только адекватных вариантов без блесени и бактериалки я в магазах не встречал.